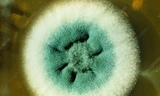
Nấm Aspergillus fumigatus được quan sát bằng kính hiển vi. Ảnh: sciencephoto.com

Theo một nghiên cứu của các chuyên gia tại Đại học Fudan và Đại học Tongji ở Thượng Hải (Trung Quốc), 182 ca nhập viện và ổ bệnh liên quan đến nấm Candida auris đã được báo cáo trên khắp cả nước vào năm 2023, cao hơn so với 33 ca trong năm 2022.
Trong khi tỷ lệ mắc bệnh ở Trung Quốc thấp hơn so với những gì được báo cáo ở Mỹ, Nam Phi và Ấn Độ, thì sự lây lan của Candida auris đến ít nhất 18 bệnh viện ở 10 tỉnh đã gây ra không ít lo ngại vì những khó khăn trong chẩn đoán và điều trị.
Nghiên cứu - được công bố trên tạp chí Bệnh nhiễm trùng mới - chỉ ra rằng hầu hết các chủng nấm được phân tích ở Trung Quốc đều kháng thuốc fluconazole, và 2% đến 4% không thể điều trị bằng caspofungin hoặc amphotericin B.
Hầu hết các ca bệnh ở Trung Quốc được xác định ở phía đông, tại các tỉnh có nền kinh tế tương đối phát triển, nơi các phòng thí nghiệm vi sinh lâm sàng của bệnh viện có trang thiết bị tiên tiến và đội ngũ nhân viên lành nghề.
Nghiên cứu viết: "Với những khó khăn trong việc chẩn đoán chính xác các trường hợp nhiễm C. auris, loại bệnh này có thể bị đánh giá thấp một cách đáng kể."
“Do tỷ lệ mắc bệnh ngày càng tăng trên toàn thế giới và thực tế là một số đợt bùng phát gần đây đã xảy ra ở các cơ sở chăm sóc sức khỏe, điều quan trọng là phải nâng cao nhận thức về mối đe dọa của C. auris đối với sức khỏe cộng đồng", nghiên cứu kết luận.
 |
| Nấm Candida auris. Ảnh: Getty |
Hồi tháng 3/2023, Trung tâm Kiểm soát và Phòng ngừa dịch bệnh (CDC) Mỹ cho biết số ca nhiễm nấm Candida auris đang lây lan nhanh chóng tại các cơ sở chăm sóc sức khỏe của nước này, với số ca bệnh tăng gần gấp đôi từ năm 2020 đến năm 2021.
Cụ thể, số ca nhiễm nấm năm 2018 là 330 ca. Năm 2019, con số này tăng 44% lên 476 ca. Năm 2020 là 756 ca, năm 2021 là 1.471 ca.
Báo cáo không bao gồm dữ liệu năm 2022, nhưng trang web của CDC cho thấy 2.377 trường hợp nhiễm Candida auris đã được xác nhận ở Mỹ.
Đáng lo ngại là trong năm 2021, số ca kháng echinocandin, loại thuốc thường được khuyên dùng để điều trị loại nấm này, tăng gấp 3 lần.
Theo hướng dẫn của CDC, các triệu chứng phổ biến nhất của Candida auris bao gồm sốt cao và ớn lạnh không cải thiện sau khi điều trị bằng kháng sinh đối với các trường hợp nghi ngờ nhiễm vi khuẩn. Các triệu chứng khác có thể phát triển nếu nhiễm trùng lây lan.
CDC Mỹ cho biết C. auris có thể gây nhiễm trùng máu và thậm chí tử vong.